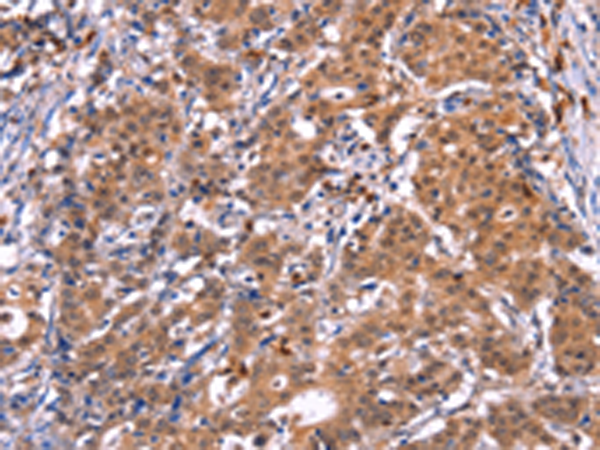

中文名稱: 兔抗GCG(GLP2)多克隆抗體
標(biāo) 記 物: Unconjugate
|
Background: |
The protein encoded by this gene is actually a preproprotein that is cleaved into four distinct mature peptides. One of these, glucagon, is a pancreatic hormone that counteracts the glucose-lowering action of insulin by stimulating glycogenolysis and gluconeogenesis. Glucagon is a ligand for a specific G-protein linked receptor whose signalling pathway controls cell proliferation. Two of the other peptides are secreted from gut endocrine cells and promote nutrient absorption through distinct mechanisms. Finally, the fourth peptide is similar to glicentin, an active enteroglucagon. |
|
Applications: |
ELISA, IHC |
|
Name of antibody: |
GCG(GLP2) |
|
Immunogen: |
Synthetic peptide of human GCG(GLP2) |
|
Full name: |
glucagon |
|
Synonyms: |
GLP1; GLP2; GRPP |
|
SwissProt: |
P01275 |
|
ELISA Recommended dilution: |
2000-5000 |
|
IHC positive control: |
Human gasrtic cancer and human thyroid cancer |
|
IHC Recommend dilution: |
50-200 |

購(gòu)物車
購(gòu)物車 幫助
幫助
 021-54845833/15800441009
021-54845833/15800441009
